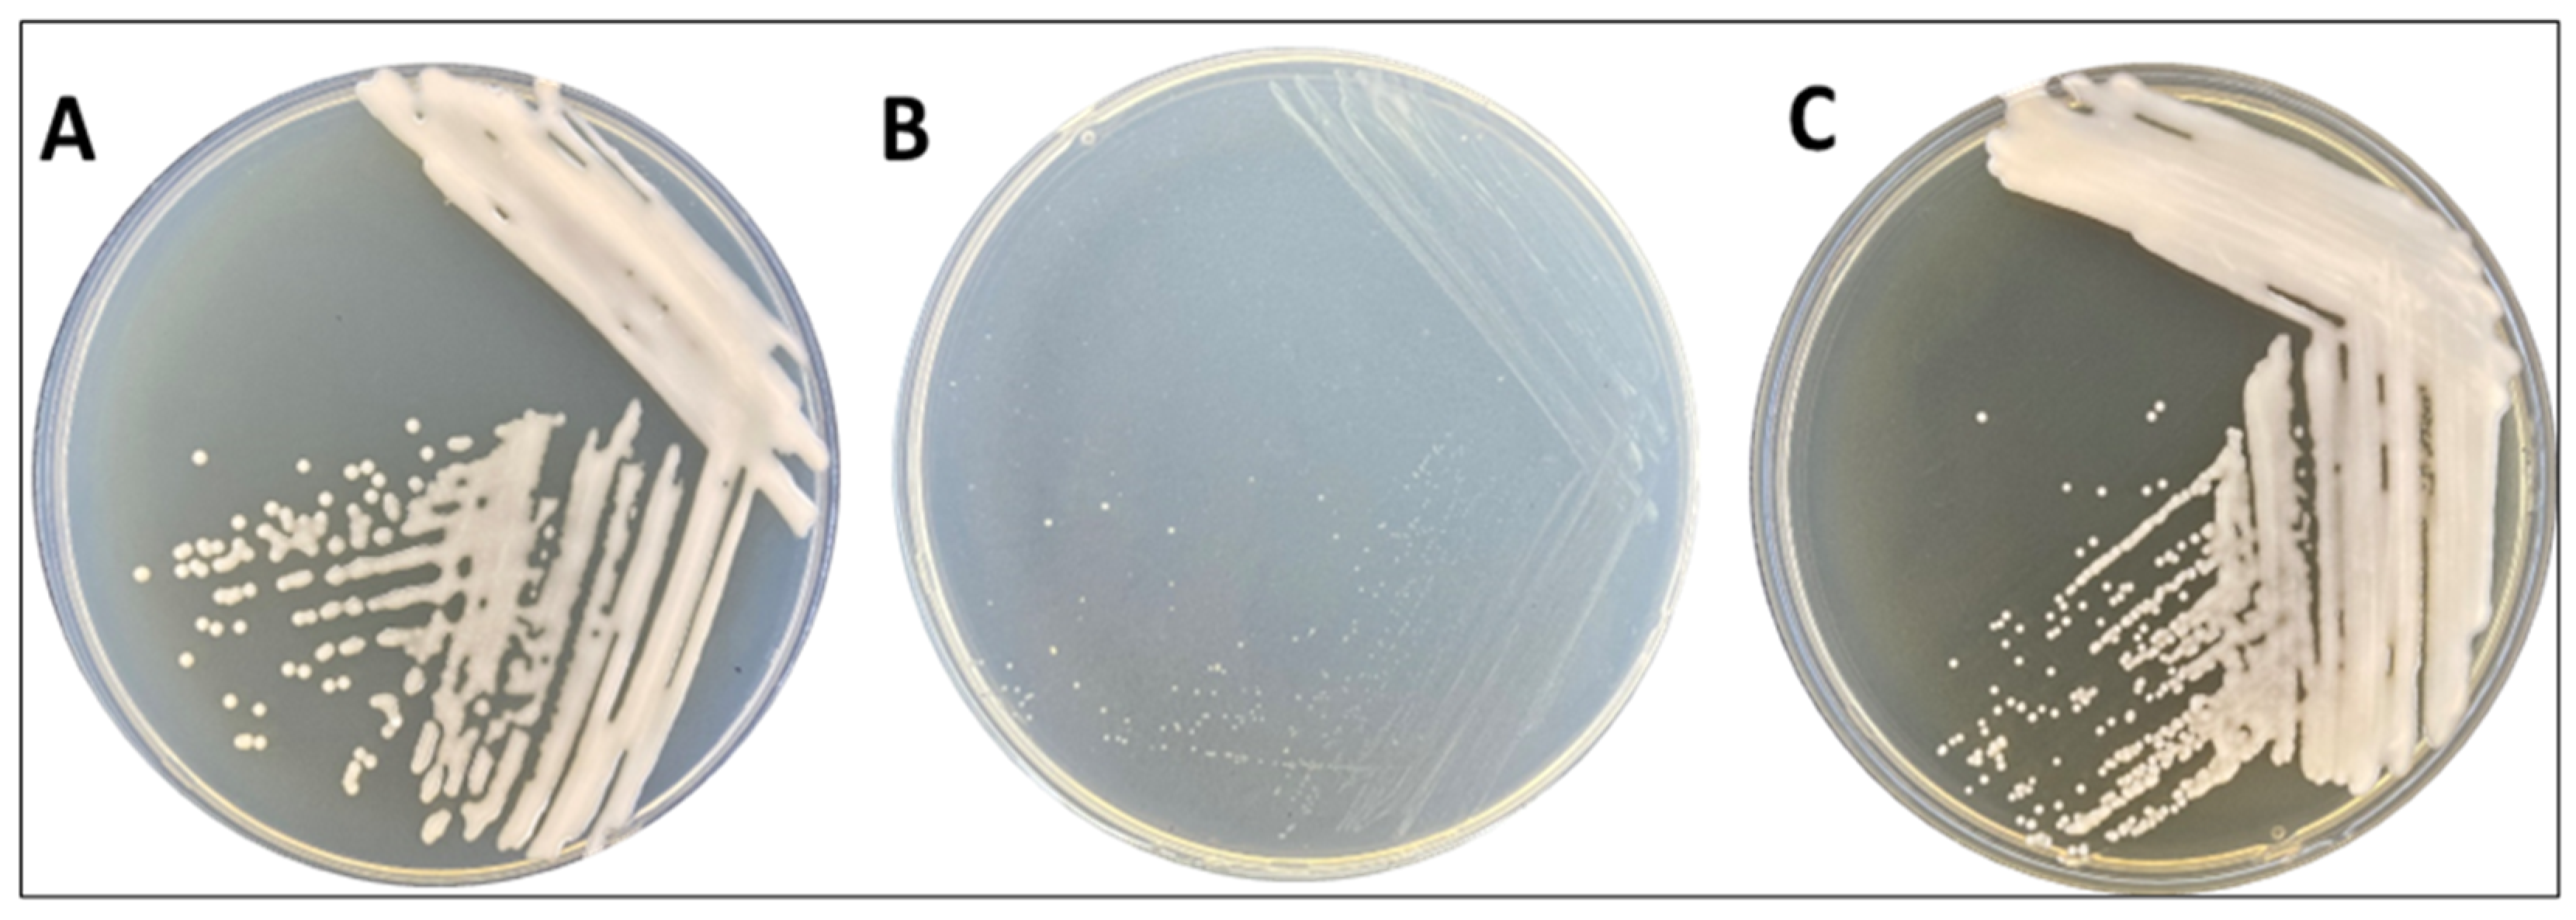
Microorganisms 12 00088 g001

Biotechnological Key Genes of the Rhodococcus erythropolis MGMM8 Genome: Genes for Bioremediation, Antibiotics, Plant Protection, and Growth Stimulation
Abstract
:1. Introduction
2. Materials and Methods
2.1. Isolation of Strain from Rhizosphere
2.2. DNA Isolation and Identification
2.3. Genome Annotation of R. erythropolis MGMM8
2.4. Screening the Potential of R. erythropolis MGMM8 to Produce Biosurfactant
2.4.1. Cell-Free Preparation
2.4.2. Drop Collapse Assay
2.4.3. Oil Displacement Test
2.4.4. Bio-Emulsification Index
3. Results
3.1. Morphological Characteristics and Genomic Features of R. erythropolis MGMM8
3.2. Comparison of Secondary Metabolite Gene Clusters in Chromosomal Genomes
3.3. Comparison of Antimicrobial Genes Clusters in Chromosomal Genomes
3.4. Annotation of Key Genes in R. erythropolis MGMM8 Involved in the Degradation of Contaminants
3.5. Biosurfactant Production of R. erythropolis MGMM8
4. Discussion
5. Conclusions
Supplementary Materials
Author Contributions
Funding
Institutional Review Board Statement
Informed Consent Statement
Data Availability Statement
Conflicts of Interest
References
- Khan, N.F.; Rasool, A.; Mansoor, S.; Saleem, S.; Baba, T.R.; Haq, S.M.; Rehman, S.A.; Adetunji, C.O.; Popesc, S.M. Potential applications of Rhizobacteria as eco-friendly biological control, plant growth promotion and soil metal bioremediation. In Sustainable Crop Production Recent Advances; Chapter 7; IntechOpen: London, UK, 2022; Volume 1, pp. 104–170. [Google Scholar]
- Cappelletti, M.; Presentato, A.; Piacenza, E.; Firrincieli, A.; Turner, R.J.; Zannoni, D. Biotechnology of Rhodococcus for the production of valuable compounds. Appl. Microbiol. Biotechnol. 2020, 104, 8567–8594. [Google Scholar] [CrossRef] [PubMed]
- Wang, H.; Liu, R.; You, M.P.; Barbetti, M.J.; Chen, Y. Pathogen biocontrol using plant growth-promoting bacteria (PGPR): Role of bacterial diversity. Microorganisms 2021, 9, 1988. [Google Scholar] [CrossRef] [PubMed]
- Akbar, A.; Khan, G.I.; Shafee, M.; Samad, A.; Masood, H.; Khan, S.A. Biocontrol of Aflatoxin through Biodegradation by Using Environment Friendly Microbes. Pol. J. Environ. Stud. 2022, 31, 4985–4988. [Google Scholar] [CrossRef] [PubMed]
- Barbey, C.; Crépin, A.; Bergeau, D.; Ouchiha, A.; Mijouin, L.; Taupin, L.; Orange, N.; Feuilloley, M.; Dufour, A.; Burini, J.F.; et al. In planta biocontrol of Pectobacterium atrosepticum by Rhodococcus erythropolis involves silencing of pathogen communication by the rhodococcal gamma-lactone catabolic pathway. PLoS ONE 2013, 8, e66642. [Google Scholar] [CrossRef] [PubMed]
- Kuyukina, M.S.; Ivshina, I.B. Bioremediation of contaminated environments using Rhodococcus. In Biology of Rhodococcus; Springer: Cham, Switzerland, 2019; Volume 16, pp. 231–270. [Google Scholar] [CrossRef]
- De Carvalho, C.C.; Fatal, V.; Alves, S.S.; Da Fonseca, M.M.R. Adaptation of Rhodococcus erythropolis cells to high concentrations of toluene. Appl. Microbiol. Biotechnol. 2007, 76, 1423–1430. [Google Scholar] [CrossRef]
- de Carvalho, C.C.; Wick, L.Y.; Heipieper, H.J. Cell wall adaptations of planktonic and biofilm Rhodococcus erythropolis cells to growth on C5 to C16 n-alkane hydrocarbons. Appl. Microbiol. Biotechnol. 2009, 82, 311–320. [Google Scholar] [CrossRef] [PubMed]
- Wei, Y.; Chen, J.; Wang, Y.; Meng, T.; Li, M. Bioremediation of the petroleum contaminated desert steppe soil with Rhodococcus erythropolis KB1 and its effect on the bacterial communities of the soils. Geomicrobiol. J. 2021, 38, 842–849. [Google Scholar] [CrossRef]
- Hidalgo, A.L.M.P.J.A.; Lopategi, A.; Prieto, M.; Serra, J.; Llama, M. Formaldehyde removal in synthetic and industrial wastewater by Rhodococcus erythropolis UPV-1. Appl. Microbiol. Biotechnol. 2002, 58, 260–264. [Google Scholar] [CrossRef]
- Zang, H.; Wang, H.; Miao, L.; Cheng, Y.; Zhang, Y.; Liu, Y.; Sun, S.; Wang, Y.; Li, C. Carboxylesterase, a de-esterification enzyme, catalyzes the degradation of chlorimuron-ethyl in Rhodococcus erythropolis D310-1. J. Hazard. Mater. 2020, 387, 121684. [Google Scholar] [CrossRef]
- Hu, X.; Li, D.; Qiao, Y.; Wang, X.; Zhang, Q.; Zhao, W.; Huang, L. Purification, characterization and anticancer activities of exopolysaccharide produced by Rhodococcus erythropolis HX-2. Int. J. Biol. Macromol. 2020, 145, 646–654. [Google Scholar] [CrossRef]
- Lang, J.; Vigouroux, A.; Planamente, S.; El Sahili, A.; Blin, P.; Aumont-Nicaise, M.; Dessaux, Y.; Morera, S.; Faure, D. Agrobacterium uses a unique ligand-binding mode for trapping opines and acquiring a competitive advantage in the niche construction on plant host. PLoS Pathog. 2014, 10, e1004444. [Google Scholar] [CrossRef] [PubMed]
- Kwasiborski, A.; Mondy, S.; Chong, T.M.; Chan, K.G.; Beury-Cirou, A.; Faure, D. Core genome and plasmidome of the quorum-quenching bacterium Rhodococcus erythropolis. Genetica 2015, 143, 253–261. [Google Scholar] [CrossRef] [PubMed]
- Weisburg, W.G.; Barns, S.M.; Pelletier, D.A.; Lane, D.J. 16S ribosomal DNA amplification for phylogenetic study. J. Bacteriol. 1991, 173, 697–703. [Google Scholar] [CrossRef] [PubMed]
- Brown, J.; Pirrung, M.; McCue, L.A. FQC Dashboard: Integrates FastQC results into a web-based, interactive, and extensible FASTQ quality control tool. Bioinformatics 2017, 33, 3137–3139. [Google Scholar] [CrossRef] [PubMed]
- Wick, R.R.; Judd, L.M.; Gorrie, C.L.; Holt, K.E. Unicycler: Resolving bacterial genome assemblies from short and long sequencing reads. PLoS Comput. Biol. 2017, 13, e1005595. [Google Scholar] [CrossRef]
- Bankevich, A.; Nurk, S.; Antipov, D.; Gurevich, A.A.; Dvorkin, M.; Kulikov, A.S.; Lesin, V.M.; Nikolenko, S.I.; Pham, S.; Prjibelski, A.D.; et al. SPAdes: A new genome assembly algorithm and its applications to single-cell sequencing. J. Comput. Biol. 2012, 19, 455–477. [Google Scholar] [CrossRef]
- Prjibelski, A.; Antipov, D.; Meleshko, D.; Lapidus, A.; Korobeynikov, A. Using SPAdes de novo assembler. Curr. Protoc. 2020, 70, e102. [Google Scholar] [CrossRef]
- Jain, C.; Rodriguez-R, L.M.; Phillippy, A.M.; Konstantinidis, K.T.; Aluru, S. High throughput ANI analysis of 90K prokaryotic genomes reveals clear species boundaries. Nat. Commun. 2018, 9, 5114. [Google Scholar] [CrossRef]
- Chen, K.T.; Lu, C.L. CSAR-web: A web server of contig scaffolding using algebraic rearrangements. Nucleic Acids Res. 2018, 4, W55–W59. [Google Scholar] [CrossRef]
- Chu, C.; Li, X.; Wu, Y. GAPPadder: A sensitive approach for closing gaps on draft genomes with short sequence reads. BMC Genom. 2019, 20, 426. [Google Scholar] [CrossRef]
- de Sa, P.H.; Miranda, F.; Veras, A.; de Melo, D.M.; Soares, S.; Pinheiro, K.; Guimaraes, L.; Azevedo, V.; Silva, A.; Ramos, R.T. GapBlaster—A graphical gap filler for prokaryote genomes. PLoS ONE 2016, 11, e0155327. [Google Scholar] [CrossRef] [PubMed]
- Blin, K.; Shaw, S.; Steinke, K.; Villebro, R.; Ziemert, N.; Lee, S.Y.; Medema, M.H.; Weber, T. antiSMASH 5.0: Updates to the secondary metabolite genome mining pipeline. Nucleic Acids Res. 2019, 47, W81–W87. [Google Scholar] [CrossRef] [PubMed]
- Alcock, B.P.; Raphenya, A.R.; Lau, T.T.; Tsang, K.K.; Bouchard, M.; Edalatmand, A.; Huynh, W.; Nguyen, A.L.V.; Cheng, A.A.; Liu, S.; et al. CARD 2020: Antibiotic resistome surveillance with the comprehensive antibiotic resistance database. Nucleic Acids Res. 2020, 48, D517–D525. [Google Scholar] [CrossRef] [PubMed]
- Sun, J.; Lu, F.; Luo, Y.; Bie, L.; Xu, L.; Wang, Y. OrthoVenn3: An integrated platform for exploring and visualizing orthologous data across genomes. Nucleic Acids Res. 2023, 51, W397–W403. [Google Scholar] [CrossRef] [PubMed]
- Ohno, A.; Ano, T.; Shoda, N. Production of antifungal peptide antibiotics iturin by Bacillus subtilis NB22 in solid state fermentation. J. Ferment. Bioeng. 1993, 75, 23–27. [Google Scholar] [CrossRef]
- Rodrigues, L.; Banat, I.M.; Teixeira, J.; Oliveira, R. Biosurfactants: Potential applications in medicine. J. Antimicrob. Chemother. 2006, 57, 609–618. [Google Scholar] [CrossRef] [PubMed]
- Cooper, D.G.; Goldenberg, B.G. Surface active agents from Bacillus species. Appl. Environ. Microbiol. 1987, 53, 224–229. [Google Scholar] [CrossRef]
- Kato, N.; Shirakawa, K.; Kobayashi, H.; Sakazawa, C. The dismutation of aldehydes by a bacterial enzyme. Agric. Biol. Chem. 1983, 47, 39–46. [Google Scholar] [CrossRef]
- Nazari, M.T.; Simon, V.; Machado, B.S.; Crestani, L.; Marchezi, G.; Concolato, G.; Ferrari, V.; Colla, L.M.; Piccin, J.S. Rhodococcus: A promising genus of actinomycetes for the bioremediation of organic and inorganic contaminants. J. Environ. Manag. 2022, 323, 116220. [Google Scholar] [CrossRef]
- Wang, L.; Zhang, C.; Zhang, J.; Rao, Z.; Xu, X.; Mao, Z.; Chen, X. Epsilon-poly-L-lysine: Recent advances in biomanufacturing and applications. Front. Bioeng. 2021, 9, 748976. [Google Scholar] [CrossRef]
- Wang, L.; Yang, H.; Wu, M.; Zhang, J.; Zhang, H.; Mao, Z.; Chen, X. Integrative transcriptome and proteome revealed high-yielding mechanisms of epsilon-poly-L-lysine by Streptomyces albulus. Front. Microbiol. 2023, 14, 1123050. [Google Scholar] [CrossRef] [PubMed]
- Nakano, H.; Tomita, F.; Suzuki, T. Biosynthesis of corynecins by Corynebacterium hydrocarboclastus: On the origin of the N-acyl group. Agric. Biol. Chem. 1976, 40, 331–336. [Google Scholar] [CrossRef]
- Suzuki, T.; Honda, H.; Katsumata, R. Production of antibacterial compounds analogous to chloramphenicol by an-paraffin-grown bacterium. Agric. Biol. Chem. 1972, 36, 2223–2228. [Google Scholar] [CrossRef]
- Undabarrena, A.; Valencia, R.; Cumsille, A.; Zamora-Leiva, L.; Castro-Nallar, E.; Barona-Gomez, F.; Cámara, B. Rhodococcus comparative genomics reveals a phylogenomic-dependent non-ribosomal peptide synthetase distribution: Insights into biosynthetic gene cluster connection to an orphan metabolite. Microb. Genom. 2021, 7, 000621. [Google Scholar] [CrossRef] [PubMed]
- Retamal-Morales, G.; Senges, C.H.R.; Stapf, M.; Olguín, A.; Modak, B.; Bandow, J.E.; Tischler, D.; Schlömann, M.; Levicán, G. Isolation and characterization of arsenic-binding siderophores from Rhodococcus erythropolis S43: Role of heterobactin B and other heterobactin variants. Appl. Microbiol. Biotechnol. 2021, 105, 1731–1744. [Google Scholar] [CrossRef] [PubMed]
- Torres-Rodriguez, J.A.; Reyes-Pérez, J.J.; Quiñones-Aguilar, E.E.; Hernandez-Montiel, L.G. Actinomycete potential as biocontrol agent of phytopathogenic fungi: Mechanisms, source, and applications. Plants 2022, 11, 3201. [Google Scholar] [CrossRef] [PubMed]
- Balabanova, L.; Nedashkovskaya, O.; Otstavnykh, N.; Isaeva, M.; Kolpakova, O.; Pentehina, I.; Seitkalieva, A.; Noskova, Y.; Stepochkina, V.; Son, O.; et al. Computational Insight into Intraspecies Distinctions in Pseudoalteromonas distincta: Carotenoid-like Synthesis Traits and Genomic Heterogeneity. Int. J. Mol. Sci. 2023, 24, 4158. [Google Scholar] [CrossRef] [PubMed]
- Reshetnikov, A.S.; Khmelenina, V.N.; Mustakhimov, I.I.; and Trotsenko, Y.A. Genes and enzymes of ectoine biosynthesis in halotolerant methanotrophs. Meth. Enzymol. 2011, 495, 15–30. [Google Scholar] [CrossRef]
- Ning, Y.; Wu, X.; Zhang, C.; Xu, Q.; Chen, N.; Xie, X. Pathway construction and metabolic engineering for fermentative production of ectoine in Escherichia coli. Metab. Eng. 2016, 36, 10–18. [Google Scholar] [CrossRef]
- Lazos, O.; Tosin, M.; Slusarczyk, A.L.; Boakes, S.; Cortés, J.; Sidebottom, P.J.; Leadlay, P.F. Biosynthesis of the putative siderophore erythrochelin requires unprecedented crosstalk between separate nonribosomal peptide gene clusters. Chem. Biol. 2010, 17, 160–173. [Google Scholar] [CrossRef]
- Williams, J.C.; Sheldon, J.R.; Imlay, H.D.; Dutter, B.F.; Draelos, M.M.; Skaar, E.P.; Sulikowski, G.A. Synthesis of the siderophore coelichelin and its utility as a probe in the study of bacterial metal sensing and response. Org. Lett. 2019, 21, 679–682. [Google Scholar] [CrossRef] [PubMed]
- Engelhart-Straub, S.; Cavelius, P.; Hölzl, F.; Haack, M.; Awad, D.; Brueck, T.; Mehlmer, N. Effects of Light on Growth and Metabolism of Rhodococcus erythropolis. Microorganisms 2022, 10, 1680. [Google Scholar] [CrossRef] [PubMed]
- Dat, T.T.H.; Oanh, P.T.T.; Cuong, L.C.V.; Anh, L.T.; Minh, L.T.H.; Ha, H.; Lam, L.T.; Cuong, P.V.; Anh, H.L.T. Pharmacological properties, volatile organic compounds, and genome sequences of bacterial endophytes from the mangrove plant Rhizophora apiculata Blume. Antibiotics 2021, 10, 1491. [Google Scholar] [CrossRef] [PubMed]
- Song, Y.; Xu, X.; Huang, Z.; Xiao, Y.; Yu, K.; Jiang, M.; Yin, S.; Zheng, M.; Meng, H.; Han, Y.; et al. Genomic Characteristics and Pan-Genome Analysis of Rhodococcus equi. Front. Cell. Infect. Microbiol. 2022, 12, 807610. [Google Scholar] [CrossRef]
- Lessmeier, L.; Hoefener, M.; Wendisch, V.F. Formaldehyde degradation in Corynebacterium glutamicum involves acetaldehyde dehydrogenase and mycothiol-dependent formaldehyde dehydrogenase. Microbiology 2013, 159 Pt 12, 2651–2662. [Google Scholar] [CrossRef]
- Morales, P.; Cáceres, M.; Scott, F.; Díaz-Robles, L.; Aroca, G.; Vergara-Fernández, A. Biodegradation of benzo [α] pyrene, toluene, and formaldehyde from the gas phase by a consortium of Rhodococcus erythropolis and Fusarium solani. Appl. Microbiol. Biotechnol. 2017, 101, 6765–6777. [Google Scholar] [CrossRef]
- Xu, X.; Ye, T.; Zhang, W.; Zhou, T.; Zhou, X.; Dai, W.; Chen, S. Identification of FadT as a novel quorum quenching enzyme for the degradation of diffusible signal factor in Cupriavidus pinatubonensis strain HN-2. Int. J. Mol. Sci. 2021, 22, 986. [Google Scholar] [CrossRef]
- Tao, F.; Zhao, P.; Li, Q.; Su, F.; Yu, B.; Ma, C.; Tang, H.; Tai, C.; Wu, G.; Xu, P. Genome sequence of Rhodococcus erythropolis XP, a biodesulfurizing bacterium with industrial potential. J. Bacteriol. 2011, 193, 6422–6423. [Google Scholar] [CrossRef]
- Corda, D.; Mosca, M.G.; Ohshima, N.; Grauso, L.; Yanaka, N.; Mariggiò, S. The emerging physiological roles of the glycerophosphodiesterase family. FEBS J. 2014, 281, 998–1016. [Google Scholar] [CrossRef]
- Bhadra, S.; Chettri, D.; Kumar Verma, A. Biosurfactants: Secondary metabolites involved in the process of bioremediation and biofilm removal. Appl. Biochem. Biotechnol. 2023, 195, 5541–5567. [Google Scholar] [CrossRef]
- de Lemos, E.A.; da Silva, M.B.F.; Coelho, F.S.; Jurelevicius, D.; Seldin, L. The role and potential biotechnological applications of biosurfactants and bioemulsifiers produced by psychrophilic/psychrotolerant bacteria. Polar Biol. 2023, 46, 397–407. [Google Scholar] [CrossRef]
- Sałek, K.; Euston, S.R. Sustainable microbial biosurfactants and bioemulsifiers for commercial exploitation. Process Biochem. 2019, 85, 143–155. [Google Scholar] [CrossRef]
- Philp, J.; Kuyukina, M.; Ivshina, I.; Dunbar, S.; Christofi, N.; Lang, S.; Wray, V. Alkanotrophic Rhodococcus ruber as a biosurfactant producer. Appl. Microbiol. Biotechnol. 2002, 59, 318–324. [Google Scholar] [CrossRef] [PubMed]
- Tokumoto, Y.; Nomura, N.; Uchiyama, H.; Imura, T.; Morita, T.; Fukuoka, T.; Kitamoto, D. Structural characterization and surface-active properties of a succinoyl trehalose lipid produced by Rhodococcus sp. SD-74. J. Oleo Sci. 2009, 58, 97–102. [Google Scholar] [CrossRef] [PubMed]
- Franzetti, A.; Gandolfi, I.; Bestetti, G.; Smyth, T.; Banat, I. Production and applications trehalose lipid biosurfactants. Eur. J. Lipid Sci. Technol. 2010, 120, 617–627. [Google Scholar] [CrossRef]
- Petrikov, K.; Delegan, Y.; Surin, A.; Ponamoreva, O.; Puntus, I.; Filonov, A.; Boronin, A. Glycolipids of Pseudomonas and Rhodococcus oil-degrading bacteria used in bioremediation preparations: Formation and structure. Process. Biochem. 2013, 48, 931–935. [Google Scholar] [CrossRef]
- Zheng, C.; Shuguang, L.; Li, Y.; Lixin, H.; Qinghong, W. Study of the biosurfactant-producing profile in a newly isolated Rhodococcus ruber strain. Ann. Microbiol. 2009, 59, 771–777. [Google Scholar] [CrossRef]
- Sadouk, Z.; Hacene, H.; Tazerouti, A. Biosurfactants production from low cost substrate and degradation of diesel oil by a Rhodococcus strain. Oil Gas Sci. Technol. 2008, 63, 747–753. [Google Scholar] [CrossRef]
- Pirog, T.; Sofilkanych, A.; Konon, A.; Shevchuk, T.; Ivanov, S. Intensification of surfactants’ synthesis by Rhodococcus erythropolis IMV Ac-5017, Acinetobacter calcoaceticus IMV B-7241 and Nocardia vaccinii K-8 on fried oil and glycerol containing medium. Food Bioprod. Process. 2013, 91, 149–157. [Google Scholar] [CrossRef]
- Nishanthi, R.; Kumaran, S.; Palani, P.; Chellaram, C.; Anand, T.P.; Kannan, V. Screening of Biosurfactants from Hydrocarbon Degrading Bacteria. J. Ecobiotechnol. 2010, 2, 47–53. [Google Scholar]
- Walter, V.; Syldatk, C.; Hausmann, R. Screening concepts for the isolation of biosurfactant producing microorganisms. In Biosurfactants. Advances in Experimental Medicine and Biology; Springer: Berlin/Heidelberg, Germany, 2010; Volume 672, pp. 1–13. [Google Scholar] [CrossRef]
- Morikawa, M.; Hirata, Y.; Imanaka, T. A study on the structure–function relationship of lipopeptide biosurfactants. Biochimica et Biophysica Acta (BBA). Mol. Cell Biol. Lipids 2000, 1488, 211–218. [Google Scholar] [CrossRef] [PubMed]

| Type | Most Similar Known Cluster | R. erythropolis. Strains. Presence (+) or Absence (−) of Gene Cluster | ||||
|---|---|---|---|---|---|---|
| MGMM8 | JCM 2895 | X5 | D310-1 | CCM2595 | ||
| RiPP-like | branched-chain fatty acids | + (75%) | + (75%) | + (75%) | + (75%) | + (75%) |
| LAP | diisonitrile antibiotic SF2768 | + (11%) | + (11%) | + (11%) | + (11%) | + (11%) |
| T1PKS | Unidentified | + | + | + | + | + |
| T1PKS | fulvuthiacene A/fulvuthiacene B | + (8%) | + (8%) | + (8%) | + (8%) | + (8%) |
| NAPAA | ε-Poly-l-lysine | + (100%) | + (100%) | + (100%) | + (100%) | + (100%) |
| NRP-metallophore, NRPS | erythrochelin | + (57%) | + (57%) | + (57%) | + (57%) | + (57%) |
| redox-cofactor | tetronasin | + (3%) | + (3%) | + (3%) | + (3%) | + (3%) |
| NRPS | corynecin III/corynecin I/corynecin II | + (100%) | + (100%) | + (100%) | + (100%) | + (100%) |
| NRPS-like | thiolutin | + (8%) | + (8%) | − | − | − |
| NRP-metallophore, NRPS | heterobactin A/heterobactin S2 | + (100%) | + (100%) | + (100%) | + (100%) | + (100%) |
| NRPS, terpene | SF2575 | + (6%) | + (6%) | + (6%) | + (6%) | + (6%) |
| NRPS, RRE-containing | coelichelin | + (27%) | + (27%) | + (27%) | + (27%) | + (27%) |
| NRPS | rifamorpholine A/rifamorpholine B/rifamorpholine C/rifamorpholine D/rifamorpholine E | − | + (3%) | + (3%) | + (4%) | − |
| NRPS | monensin | + (5%) | + (5%) | + (5%) | − | + (5%) |
| terpene 3 | carotenoid | + (27%) | + (27%) | + (27%) | + (27%) | + (37%) |
| ectoine | ectoine | + (75%) | + (75%) | + (75%) | + (75%) | + (75%) |
| butyrolactone | Unidentified | + | + | + | + | + |
| PKS-like, amglyccycl | acarbose | + (7%) | − | − | + (7%) | + (7%) |
| lanthipeptide-class-iii | Unidentified | + | + | + | + | + |
| NRPS | Unidentified | + | − | − | − | − |
| NRPS | polyoxin A/polyoxin H | − | + (5%) | − | − | − |
| NRPS-like | unidentified | − | − | + | + | + |
| ARO Term | AMR Gene Family | Drug Class | Resistance Mechanism | Presence (+) or Absence (−) of Antibiotic-Resistant Genes | ||||
|---|---|---|---|---|---|---|---|---|
| MGMM8 | JCM 2895 | X5 | D310-1 | CCM2595 | ||||
| VanW gene in VanI cluster | VanW, glycopeptide resistance gene cluster | glycopeptide antibiotic | antibiotic target alteration | + | + | + | + | + |
| VanY gene in VanB cluster | VanY, glycopeptide resistance gene cluster | glycopeptide antibiotic | antibiotic target alteration | + | − | − | − | + |
| iri | rifampin monooxygenase | rifamycin antibiotic | antibiotic inactivation | + | − | − | − | + |
| RbpA | RbpA bacterial RNA polymerase-binding protein | rifamycin antibiotic | antibiotic target protection | + | + | + | + | + |
| Mycobacterium tuberculosis folC with mutation conferring resistance to para-aminosalicylic acid | aminosalicylate resistant dihydrofolate synthase | salicylic acid antibiotic | antibiotic target alteration | + | + | + | + | + |
| Streptomyces venezuelae rox | rifampin monooxygenase | rifamycin antibiotic | antibiotic inactivation | − | + | + | + | − |
Disclaimer/Publisher’s Note: The statements, opinions and data contained in all publications are solely those of the individual author(s) and contributor(s) and not of MDPI and/or the editor(s). MDPI and/or the editor(s) disclaim responsibility for any injury to people or property resulting from any ideas, methods, instructions or products referred to in the content. |
© 2023 by the authors. Licensee MDPI, Basel, Switzerland. This article is an open access article distributed under the terms and conditions of the Creative Commons Attribution (CC BY) license (https://creativecommons.org/licenses/by/4.0/).
Share and Cite
Afordoanyi, D.M.; Akosah, Y.A.; Shnakhova, L.; Saparmyradov, K.; Diabankana, R.G.C.; Validov, S. Biotechnological Key Genes of the Rhodococcus erythropolis MGMM8 Genome: Genes for Bioremediation, Antibiotics, Plant Protection, and Growth Stimulation. Microorganisms 2024, 12, 88. https://doi.org/10.3390/microorganisms12010088
Afordoanyi DM, Akosah YA, Shnakhova L, Saparmyradov K, Diabankana RGC, Validov S. Biotechnological Key Genes of the Rhodococcus erythropolis MGMM8 Genome: Genes for Bioremediation, Antibiotics, Plant Protection, and Growth Stimulation. Microorganisms. 2024; 12(1):88. https://doi.org/10.3390/microorganisms12010088
Chicago/Turabian StyleAfordoanyi, Daniel Mawuena, Yaw Abayie Akosah, Lidiya Shnakhova, Keremli Saparmyradov, Roderic Gilles Claret Diabankana, and Shamil Validov. 2024. "Biotechnological Key Genes of the Rhodococcus erythropolis MGMM8 Genome: Genes for Bioremediation, Antibiotics, Plant Protection, and Growth Stimulation" Microorganisms 12, no. 1: 88. https://doi.org/10.3390/microorganisms12010088
APA StyleAfordoanyi, D. M., Akosah, Y. A., Shnakhova, L., Saparmyradov, K., Diabankana, R. G. C., & Validov, S. (2024). Biotechnological Key Genes of the Rhodococcus erythropolis MGMM8 Genome: Genes for Bioremediation, Antibiotics, Plant Protection, and Growth Stimulation. Microorganisms, 12(1), 88. https://doi.org/10.3390/microorganisms12010088

